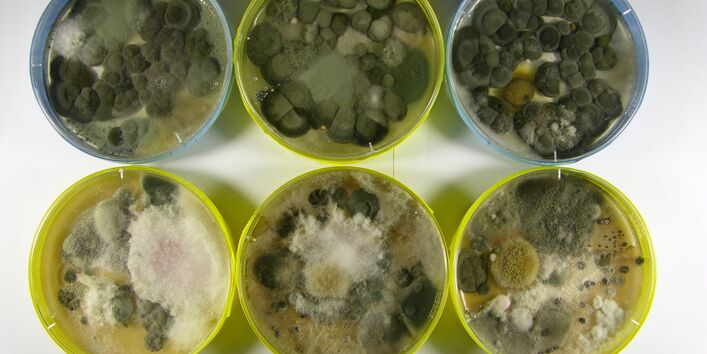
Unterschiedliche Schimmelpilze in Anzuchtschalen

(nach: Donadio, S., Gabrio, T., Kussauer, R., Lerch, P., Wiesmüller GA. (2016) Feuchtigkeit und Schimmelbildung. Verbraucherzentrale NRW, Düsseldorf ISBN 978-3-86336-060-3)
Einen Arzt zu finden, der sich mit Schimmel in Innenräumen und möglichen damit zusammenhängenden Gesundheitsbeschwerden auskennt, ist nicht einfach. Es gibt keine Zusatzbezeichnung für Ärzte, die sich direkt auf die Schimmelproblematik bezieht.
Zudem sind Ärzten bei der Werbung enge Grenzen gesetzt.
Die folgenden Hinweise können Ihnen dabei helfen, einen guten Arzt zu finden.
Ein qualifizierter Arzt kann Weiterbildungen, Qualifikationen und Tätigkeitsschwerpunkte nachweisen, zum Beispiel in den Bereichen
- Umweltmedizin;
- Hygiene und Umweltmedizin;
- Innere Medizin und Pneumologie (Lungenheilkunde);
- Allergologie;
- Hals-Nasen-Ohrenheilkunde;
- Haut- und Geschlechtskrankheiten;
- Mikrobiologie;
- Virologie und Infektionsepidemiologie;
- Arbeitsmedizin;
- Infektiologie.
Auch die Zugehörigkeit zu einer medizinischen Fachgesellschaft weist auf entsprechende Arbeitsschwerpunkte hin. Relevant sind zum Beispiel die
- Deutsche Gesellschaft für Pneumologie;
- Deutsche Gesellschaft für Hals-Nasen-Ohren-Heilkunde;
- Deutsche Gesellschaft für Dermatologie;
- Deutsche Gesellschaft für Allergologie und klinische Immunologie;
- Deutsche Gesellschaft für Infektiologie;
- Gesellschaft für Hygiene, Umweltmedizin und Präventivmedizin;
- Deutsche Gesellschaft für Hygiene und Mikrobiologie;
- Deutsche Gesellschaft für Arbeitsmedizin und Umweltmedizin.
Diese Informationen können Sie in aller Regel der Internetseite des Arztes entnehmen.
Ein qualifizierter Arzt:
- verzichtet bei der Abklärung der Frage, ob ein Zusammenhang zwischen gesundheitlichen Problemen und einem Feuchte-/Schimmelschaden im Innenraum besteht, auf voreilige Schlussfolgerungen. Im ersten Schritt sollte er sorgfältig die Krankengeschichte erheben und dabei vor allem auf eine möglicherweise vorliegende Anfälligkeit für gesundheitliche Wirkungen von Schimmelpilzen achten. Dazu gehören eine besonders ausgeprägte Abwehrschwäche (zum Beispiel aufgrund einer Tumorerkrankung, Leukämie, Stammzelltransplantation, Organtransplantation, HIV-Erkrankung (AIDS)), Mukoviszidose (Zystische Fibrose) oder Asthma. Liegt bei Ihnen eine solche Anfälligkeit vor, müssen Sie unter Umständen in besonderem Maße vor weiterem Kontakt zu einem Feuchte-/Schimmelschaden im Innenraum geschützt werden. Zudem sollten mögliche andere Ursachen für die gesundheitlichen Probleme geklärt werden.
- wägt im weiteren Verlauf gemeinsam mit Ihnen sorgfältig ab, mit welchen Untersuchungsmethoden er die gesundheitlichen Probleme abklärt. Dabei sollte er sich an der Schimmelpilz-Leitlinie „Medizinisch klinische Diagnostik bei Schimmelpilzexposition in Innenräumen“ der Arbeitsgemeinschaft der Wissenschaftlichen Medizinischen Fachgesellschaften (AWMF) (AWMF-Register-Nr. 161/001) orientieren.
- klärt Sie auch über die Grenzen der heutigen Nachweisverfahren auf.
Im konkreten Einzelfall kann meist kein ursächlicher Zusammenhang zwischen dem Entstehen von gesundheitlichen Problemen und Schimmelbefall nachgewiesen werden. Der Arzt kann nur beurteilen, ob aufgrund der vorliegenden Erkrankung ein weiterer Kontakt zu Schimmel die Gesundheit beeinträchtigt. Nach heutigem Wissen können weder Allergien gegen Schimmelpilze, die bei Feuchte-/Schimmelschäden im Innenraum vorkommen, noch Schimmelpilzgiftstoffe (Mykotoxinen) im Körper zuverlässig nachgewiesen werden.
Folgende Punkte zeichnen generell einen guten Arzt aus:
- Der Arzt nimmt mich und mein spezielles gesundheitliches Problem ernst.
- Ich erhalte eine ausführliche und verständliche Information und Beratung.
- Der Arzt gibt Hinweise auf weiterführende Informationsquellen und Beratungsangebote.
- Er bezieht mich in alle Entscheidungen zu meiner gesundheitlichen Situation ein.
- Arzt und Praxispersonal behandeln mich freundlich und respektvoll.
- Ich erhalte ohne Probleme Zugang zu meinen Patientenunterlagen.
- Der Arzt akzeptiert, dass ich im Zweifelsfall eine zweite Meinung einholen möchte.
- In der Praxis werden der Schutz meiner Person und meine Intimsphäre gewahrt.
- Die Praxis schützt meine persönlichen Daten.
- Ich erkenne, ob und wie sich Arzt und Praxispersonal um die Qualität meiner Behandlung bemühen.